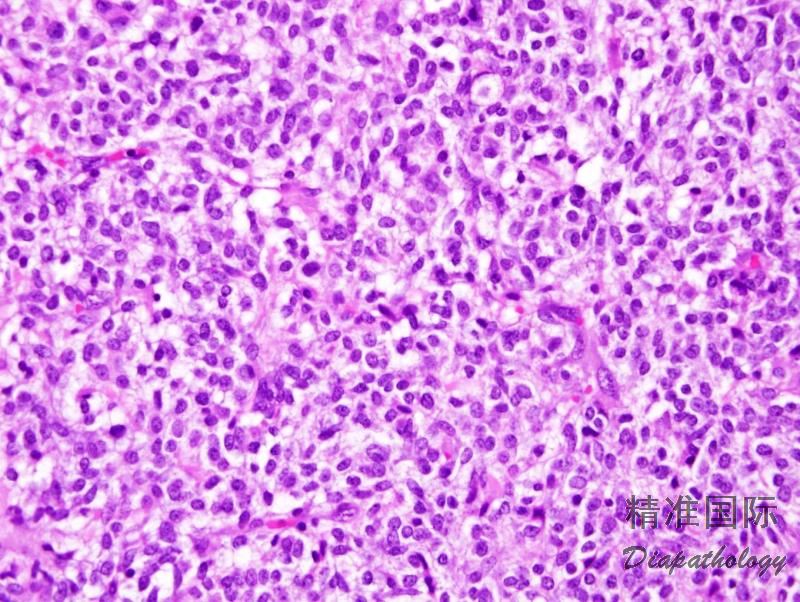

卵巢幼年型粒层细胞瘤
Juvenile Granulose Cell Tumor of the Ovary
概述:
发生于青少年的形态学及预后不同于成年型粒层细胞瘤的颗粒层细胞瘤。
发病部位: 卵巢
诊断要点:
通常发生于 30 岁以前,平均发病年龄 15 岁;
囊实性最常见,囊内可含有血性液体。也可为实性或完全囊性变;后者常为多房,罕见单房。实性区通常为黄褐色或灰白色,偶尔可见广泛的坏死和(或)出血
镜下典型表现为肿瘤细胞弥漫或结节状分布,其间穿插大小和形状不一的滤泡,但也可以是规则的圆形和卵圆形滤泡;
滤泡腔内含有嗜酸性,偶尔为嗜碱性分泌物,大约 2/3 的病例呈黏液卡红染色阳性;
滤泡内衬粒层细胞,细胞层数不同使得滤泡壁薄厚不一,周围可有卵泡膜细胞围绕,经常可见滤泡衬覆的粒层细胞与周围卵泡膜细胞区融合;
有时可见粒层细胞衬覆于假乳头结构;
极少数情况下,衬覆细胞类似于靴钉样细胞;
与成人型不同,粒层细胞核通常呈圆形、深染,罕见核沟;细胞质通常丰富、嗜酸性(黄素化);
少数病例可见小灶区域具有成人型粒层细胞瘤样形态,诊断时应以主要成分为依据;
约 10-15%的病例可见核异型,核分裂像多少不一,一般较多见;
肿瘤中的卵泡膜细胞常常黄素化,少数病例以卵泡膜细胞为主;
偶尔,粒层细胞和卵泡膜细胞错综复杂地混杂在一起;
间质常稀少,偶尔间质增生明显伴硬化,隐盖了肿瘤的特点;
有时间质可见嗜碱性基质;
罕见钙化。
极少数病例与普通肿瘤相比,肿瘤细胞核异型性十分显著,但结构规则,肿瘤中可见成片生长的区域,就像未分化癌,充分取材并发现典型的滤泡结构可诊断间变性幼年型粒层细胞瘤。

免疫组织化学染色:
Inhibin、calretinin、SF-1. CD99. CD56 常阳性,部分病例可表达低分子量角蛋白(CK8. CK18),少数表达 FOXL2。
鉴别诊断:
1. 成年型粒层细胞瘤:
成年型与幼年型粒层细胞瘤的鉴别:
| 成年型 | 幼年型 |
| 青春期前患者不到1% | 青春期前患者占50% |
| 多见于30岁后 | 多见于30岁前 |
| 可见微滤泡(Call-Exner小体) | 卵泡大小形状不一,含有黏液 ,罕见Call-Exner小体 |
| 细胞核淡染,成角,常见核沟 | 细胞核深染,圆形,罕见核沟 |
| 肿瘤细胞黄素化不常见 | 肿瘤细胞黄素化常见 |
2. 卵泡膜细胞瘤 :少数 JGCT 缺乏或罕见滤泡结构、肿瘤细胞质丰富并且偶尔以卵泡膜细胞为主。
幼年型卵泡膜细胞瘤经充分取材可找到滤泡结构;
网状纤维染色证实至少部分肿瘤细胞周围网状纤维稀少,为粒层细胞;
卵泡膜细胞瘤中核分裂像罕见,多发生 30 岁以后,与幼年型粒层细胞瘤相反;
免疫组织化学染色可助鉴别诊断。
3. 类固醇细胞瘤 :黄素化 JGCT 中局灶的弥漫性结构可能提示类固醇细胞瘤的诊断
类固醇细胞瘤的组织学结构和细胞学形态单一,这种情况 JGCT 少见;
充分取材幼年型粒层细胞瘤总会含有更具有诊断性特征的区域;
免疫组织化学染色可助鉴别诊断。
预后:
有很高的治愈率,与成人型通常晚期复发相反,所有临床过程为恶性的病例在 3 年内复发,并且有的临床进展非常快。
← 卵巢支持细胞瘤 卵巢成年型粒层细胞瘤 →
